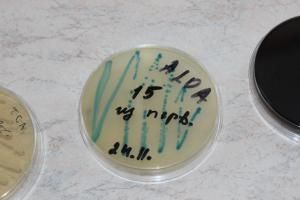
Семинар для молодых ученых: «Научно-практический центр гигиены: современный взгляд» 9 Семинар для молодых ученых: «Научно-практический центр гигиены: современный взгляд» 9

-
ЗаявленияОставьте заявку онлайн на одну из наших процедур
-
Перечень документовдля заявления на исследования для подтверждения соответствия
-
Прейскурантцены на весь перечень услуг
-
Подлежит или нет?Списки продукции, подлежащей сертификации
-
Нормативные документы
-
Сроки исполнения
-
Перечень документовдля подтверждения соответствия продукции требованиям ТР ТС
-
Электронное обращение
-
Область аккредитации